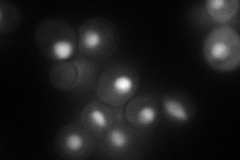
YFR013W

View description
Member of a complex (Isw1a) with Isw1p that has nucleosome-stimulated ATPase activity and represses transcription initiation by specific positioning of a promoter proximal dinucleosome; has homology to Esc8p, which is involved in silencing
Localization:
Intensity:
Fold change:
Significance:
-
C’ GFP library in SD

nucleus27.41 -
N' NOP1pr-GFP in SD
nucleus66.7833 -
N' TEF2pr-mCherry in SD

nucleus0 -
N' NATIVEpr-GFP in SD

nucleus33.7327 -
N' TEF2pr-VC and Cyto-VN in SD

nucleus37.7157 -
C’ GFP library in SD+DTT

nucleusN/AN/ANo -
C’ GFP library in SD+H2O2

nucleusN/AN/ANo -
C’ GFP library in Starvation Media

nucleusN/AN/AYes -
C’ GFP library on the background of Pup2-DaMP

nucleus -
C’ GFP library on the background of CCT mutant

nucleusN/AN/ANo
